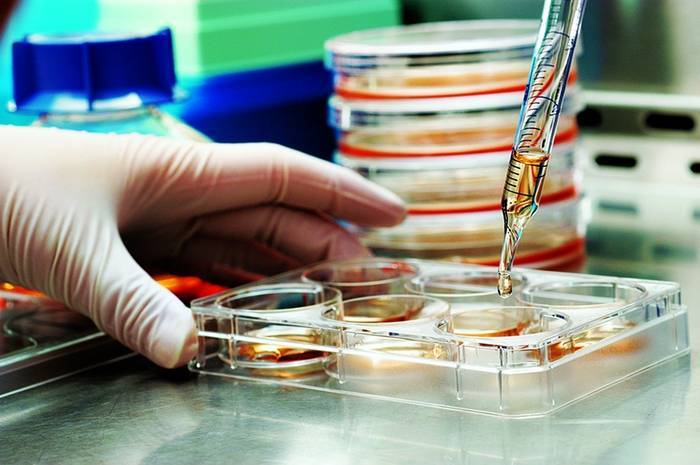

For patients who suffer from chronic pain as well as a number of other medical ailments, Stem Cell Therapy in Cincinnati has become a more popular and, at times, contentious kind of treatment over the last 20 years. Many potential patients are still unaware of how stem cell therapy functions as a result of a lot of disinformation that has given rise to various fallacies about them. Patients can decide whether and when stem cell therapy would be a useful option for pain management by being more familiar with what stem cell therapy actually is and how it works in the body.
“Stem cells are the building blocks of the body; they are the cells from which all other cells with particular roles are derived. In the correct circumstances, stem cells can divide to create new cells known as daughter cells, either in the body or in a lab.
The basic components of the human body, or “master cells” as they are sometimes known, are stem cells. These cells can differentiate into a variety of cell types, each of which has a unique set of specialised tasks. Each “master cell” generates “daughter cells” that have the capacity to develop into organs, blood, bone, and muscle, all of which are capable of mending damaged tissue. Since stem cells have the capacity to self-renew, they can also divide to produce new stem cells.
Stem cells can produce new cell kinds, unlike other types of body cells. With stem cell therapy, scientists want to harness the power that stem cells possess and use it to develop cures for a wide range of diseases and disorders.
Adult stem cells, embryonic stem cells, and induced pluripotent stem cells
The adult stem cells utilised in stem cell treatment are taken from the patient’s own fat or bone marrow, while each type of stem cell has a variety of functions. Adult stem cells have a reputation for being less adaptable than other types of stem cells, but they are also less contentious because they are extracted from patients with their informed agreement.
Nevertheless, adult stem cells have demonstrated outstanding efficacy in curing all patient complaints of pain.
An illustration of the various stem cell types found within the human body.
Due to their capacity for self-renewal and potential to speed up tissue healing, Stem Cell Therapy in Cincinnati hold the promise of innovative new treatments for a variety of illnesses.
To research and monitor the onset of disease, scientists use stem cells. Early-stage cells can be studied by scientists as they watch them grow and differentiate into other types of cells, providing a great insight of how certain disorders and diseases can manifest.
Drug safety and effectiveness are tested using stem cells. Without utilising actual test subjects, researchers can study the effects of medications using human stem cells. Data can be gathered on how the medicine is absorbed by the human stem cells as they transform into the desired form.
Aspirating stem cells from the patient’s body, which are present in fat and/or bone marrow, is the first step in stem cell therapy for the treatment of pain relief. Following that, one of four injection methods can be used to provide stem cells: intravenous injections, intra-articular injections, intramuscular injections, or an intrathecal surgery, more generally known as a lumbar puncture. Depending on where a patient’s discomfort and inflammation are, a different procedure will be chosen for them.

Because they are carried out in a minimally invasive, non-surgical technique, stem cell therapies have gained popularity over other types of pain relief. Orthopedic stem cell therapies are frequently provided in a professional or hospital setting, and the process itself usually takes no longer than 90 minutes. Particularly when compared to surgical procedures, stem cell treatments are rather painless.
After therapy, lethargy, headaches, fever, chills, and nausea are common side symptoms that few individuals suffer. The majority of the time, these side effects go away within a few hours, but for the best recovery, it is advised that patients plan on taking one week off of work after the surgery. In addition, patients are advised to limit activities in the area of the body receiving treatment for roughly one month following stem cell procedures.
It’s critical for anyone seeking stem cell therapies to be aware that there are two categories of stem cell therapies: those that have received FDA approval and those that have not. Specific forms of blood malignancies are more frequently treated using FDA-approved Stem Cell Therapy in Cincinnati. Before undergoing any stem cell treatment, patients should make sure that the clinic uses only bone marrow stem cells, as those are the only ones that have been approved for use by the FDA.
Despite the fact that it is still a relatively new form of treatment, stem cell technology has the power to produce results that are unmatched for individuals with chronic pain. In certain research trials, the success rate is as high as 70 to 80 percent of patients making a significant improvement.
Although stem cell therapies cannot repair wounds or inflammation, they have been shown to reduce pain by promoting the body’s natural healing processes, making the pain more tolerable. After receiving treatment, patients’ bodies will continue to produce new cells for up to a year, and some patients report feeling less pain in just two weeks. Others might not start to feel better for several weeks or even months. In order to hasten the healing process, physical therapy is typically advised for patients who have had any type of stem cell injection.
The long-term effects of stem cell therapy vary from patient to patient, despite the fact that it is widely acknowledged as being quite beneficial for individuals with all types of pain. Patients with arthritis, for instance, have reported outcomes lasting anywhere between six months and several years. Patients often enjoy pain relief for five to 10 years, while some clinical research claim that patients can benefit for up to fifteen years. Repeat stem cell treatments may be performed in the future, if necessary.
Although many individuals view stem cell therapy as a miracle cure, it’s vital to remember that there are certain risks involved. Stem cell therapy may not work as well for people who have blood abnormalities, infections, active malignancies, or chronic illnesses. However, using a patient’s own stem cells considerably minimises the possibility of any unfavourable side effects. Before undergoing any form of stem cell operation, it may be helpful to make an appointment with a doctor if you have questions regarding your eligibility for stem cell therapy.
Understanding how stem cell treatment actually operates and what patients can anticipate is the first step toward obtaining long-lasting pain relief, despite the fact that there has been a lot of contradictory information floating around about it. For the treatment of chronic pain, stem cell therapy is overwhelmingly secure, efficient, and minimally intrusive. Although stem cell research is still in its infancy, we are already beginning to witness its global uptake and how it is improving patients’ quality of life. For people with all kinds of illnesses and medical problems, including individuals fighting chronic pain around the world, Stem Cell Therapy in Cincinnati open up countless opportunities for healing and respite. Stem cell research has made it possible for the future to be largely pain-free.

At StemCures, we treat orthopaedic and osteoarthritis chronic pain using your body’s own natural stem cells, also known as adult stem cells. Given that these adult Stem Cell Therapy in Cincinnati naturally produced from your own body, we have complete faith in their potency.
Many of our patients have undergone successful surgeries and experienced a marked reduction in their chronic pain. Visit our testimonials page to see some of our client comments
Please get in touch with our friendly team right away to learn more about our clinic and to find out if we may assist with your chronic pain.